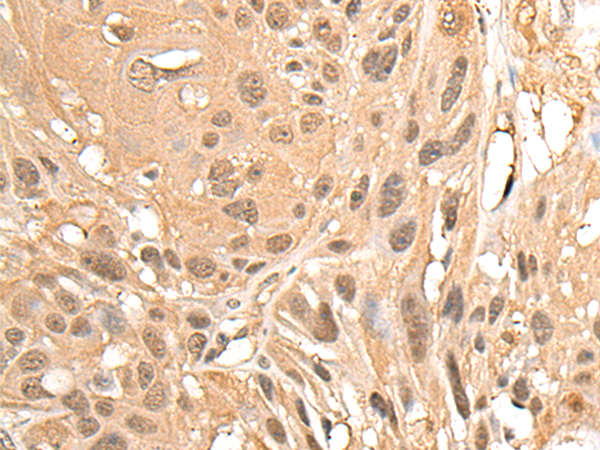
一抗

中文名稱: 兔抗MED23多克隆抗體
英文名稱: Anti-MED23 rabbit polyclonal antibody
別 名: mediator complex subunit 23 SUR2; CRSP3; MRT18; SUR-2; ARC130; CRSP130; CRSP133; DRIP130
相關類別: 一抗
儲 存: 冷凍(-20℃)
抗 原: MED23
宿 主: Rabbit
反應種屬: Human, Mouse, Rat
標 記 物: Unconjugate
克隆類型: rabbit polyclonal
技術規(guī)格
|
Background: |
The activation of gene transcription is a multistep process that is triggered by factors that recognize transcriptional enhancer sites in DNA. These factors work with co-activators to direct transcriptional initiation by the RNA polymerase II apparatus. The protein encoded by this gene is a subunit of the CRSP (cofactor required for SP1 activation) complex, which, along with TFIID, is required for efficient activation by SP1. This protein is also a component of other multisubunit complexes e.g. thyroid hormone receptor-(TR-) associated proteins which interact with TR and facilitate TR function on DNA templates in conjunction with initiation factors and cofactors. This protein also acts as a metastasis suppressor. Several alternatively spliced transcript variants encoding different isoforms have been described for this gene. |
|
Applications: |
ELISA, IHC |
|
Name of antibody: |
MED23 |
|
Immunogen: |
Synthetic peptide of human MED23 |
|
Full name: |
mediator complex subunit 23 |
|
Synonyms: |
SUR2; CRSP3; MRT18; SUR-2; ARC130; CRSP130; CRSP133; DRIP130 |
|
SwissProt: |
Q9ULK4 |
|
ELISA Recommended dilution: |
5000-10000 |
|
IHC positive control: |
Human ovarian cancer; |
|
IHC Recommend dilution: |
30-150 |

 購物車
購物車 幫助
幫助
 021-54845833/15800441009
021-54845833/15800441009